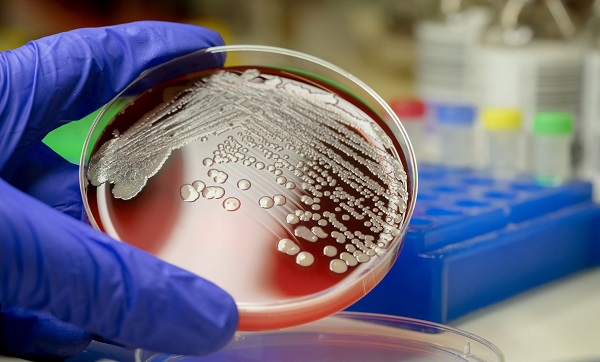
Sepsis nedir? | Koronavirüs sepsis ne demek?

Ücretsiz maske nasıl istenir? | Ücretsiz maske başvurusu
Milli İradenin Sesi Yeni Akit
Türkiye ve dünyadaki gelişmeleri yakından takip etmek için Google listenize Yeni Akit'i ekleyin.

Ücretsiz maske nasıl istenir? ePTT AvM üzerinden başlayan maske talepleri kısa sürede sistemi durma noktasına getirdi. Bu nedenle ücretsiz maske talep etme adresi değişti. Vatandaşlar, "Kimler ücretsiz maske talep edebilir?" , "Ücretsiz maske nasıl alırım?" , "Kimlere ücretsiz maske dağıtılacak?" , "Ücretsiz maske evlere mi gönderilecek?" , "Ücretsiz maske başvuru adımları" konularını araştırıyor. İşte, ücretsiz maske başvurusu.
Ücretsiz maske nasıl istenir? ePTT AvM üzerinden başlayan maske talepleri kısa sürede sistemi durma noktasına getirdi. Bu nedenle ücretsiz maske talep etme adresi değişti. Vatandaşlar, "Kimler ücretsiz maske talep edebilir?" , "Ücretsiz maske nasıl alırım?" , "Kimlere ücretsiz maske dağıtılacak?" , "Ücretsiz maske evlere mi gönderilecek?" , "Ücretsiz maske başvuru adımları" konularını araştırıyor. İşte, ücretsiz maske başvurusu.
Korononavirüs tedbirleri kapsamında vatandaşların market ve pazarlarda maske takmaları zorunlu hale getirildi. Hal böyle olunca maskeye olan ihtiyaç arttı. Evinde kal çağrılarına uyan ve maskesi bulunmayanlara ise güzel haber geldi. 20-65 yaş aralığındaki vatandaşlara ücretsiz maske dağıtımı başladı. İşte, detaylar…
PTT ücretsiz maske kimler alabilecek?
Yapılan açıklamaya göre ücretsiz maske dağıtımı 20 yaş altı ve 65 yaş üstü vatandaşları kapsamayacak. Yapılan açıklamada:
Aile üyeleriniz için maske temin etmek isterseniz, aile üyelerine ait bilgileri form üzerinde doldurarak onlara da ücretsiz maske temini sağlayabilirsiniz.
Vatandaşların her hafta “1” paket maske (5 adet) alma hakkı bulunmaktadır.
PTT Kargo ile ücretsiz olarak taşınacaktır.
Ücretsiz maske nasıl istenir? | Ücretsiz maske başvurusu
Cumhurbaşkanı Recep Tayyip Erdoğan'ın talimatıyla başlatılan ücretsiz maske dağıtımında başvurular, e-Devlet Kapısı üzerinden alınacak. "PttAVM.com" internet sitesi üzerinden yapılan duyuruda, Sağlık Bakanlığı ile Ulaştırma ve Altyapı Bakanlığının koordinasyonunda "https://maske.epttavm.com" üzerinden yapılacak başvurulara kısa sürede yoğun bir ilgi olduğu belirtildi.
Duyuruda, "Sizlere daha sağlıklı hizmet sunabilmek adına, ücretsiz maske taleplerinize ilişkin başvurularınızı en kısa sürede e-Devlet Kapısı üzerinden alacağımızı bildirmek isteriz. Anlayışınız için teşekkür ederiz." ifadelerine yer verildi.
Maskelerin, 20-65 yaş arasındaki her vatandaşa ücretsiz olarak dağıtılacağı açıklanmıştı.
MASKE BAŞVURUSU İÇİN TIKLAYINIZ